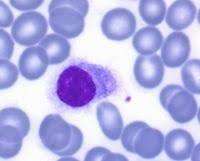
Leucemia de células pilosas
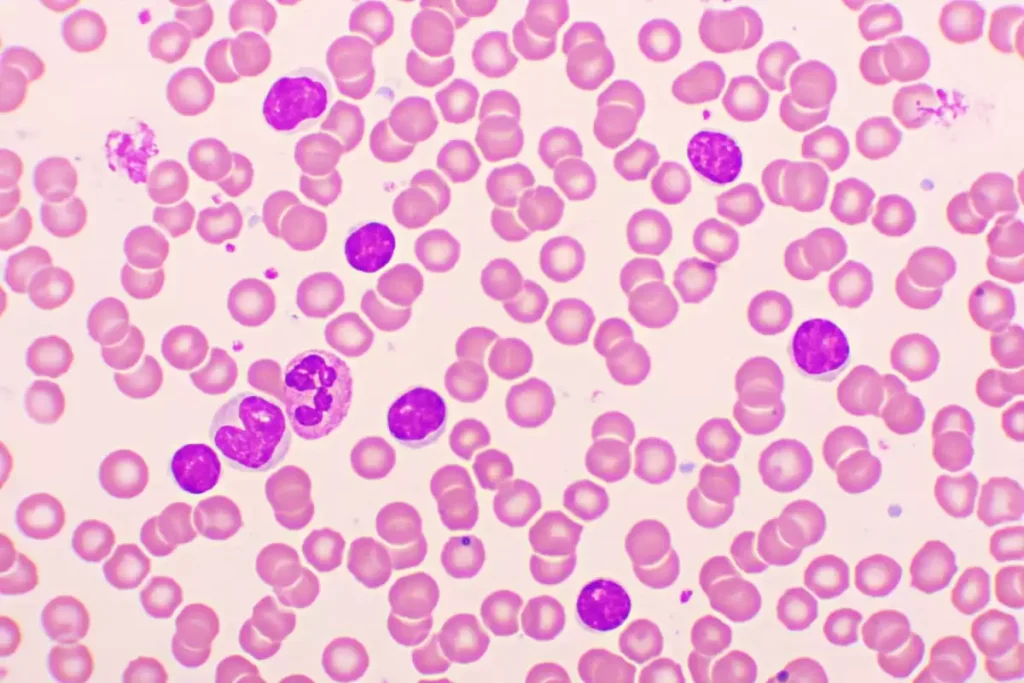
Leucemia linfocítica crónica

Publicado enFisiología
Prevención de la pérdida excesiva de sodio en la orina
La prevención de la pérdida urinaria excesiva de sodio constituye uno de los pilares fisiológicos más críticos para la estabilidad del volumen extracelular y del volumen plasmático, porque el sodio…